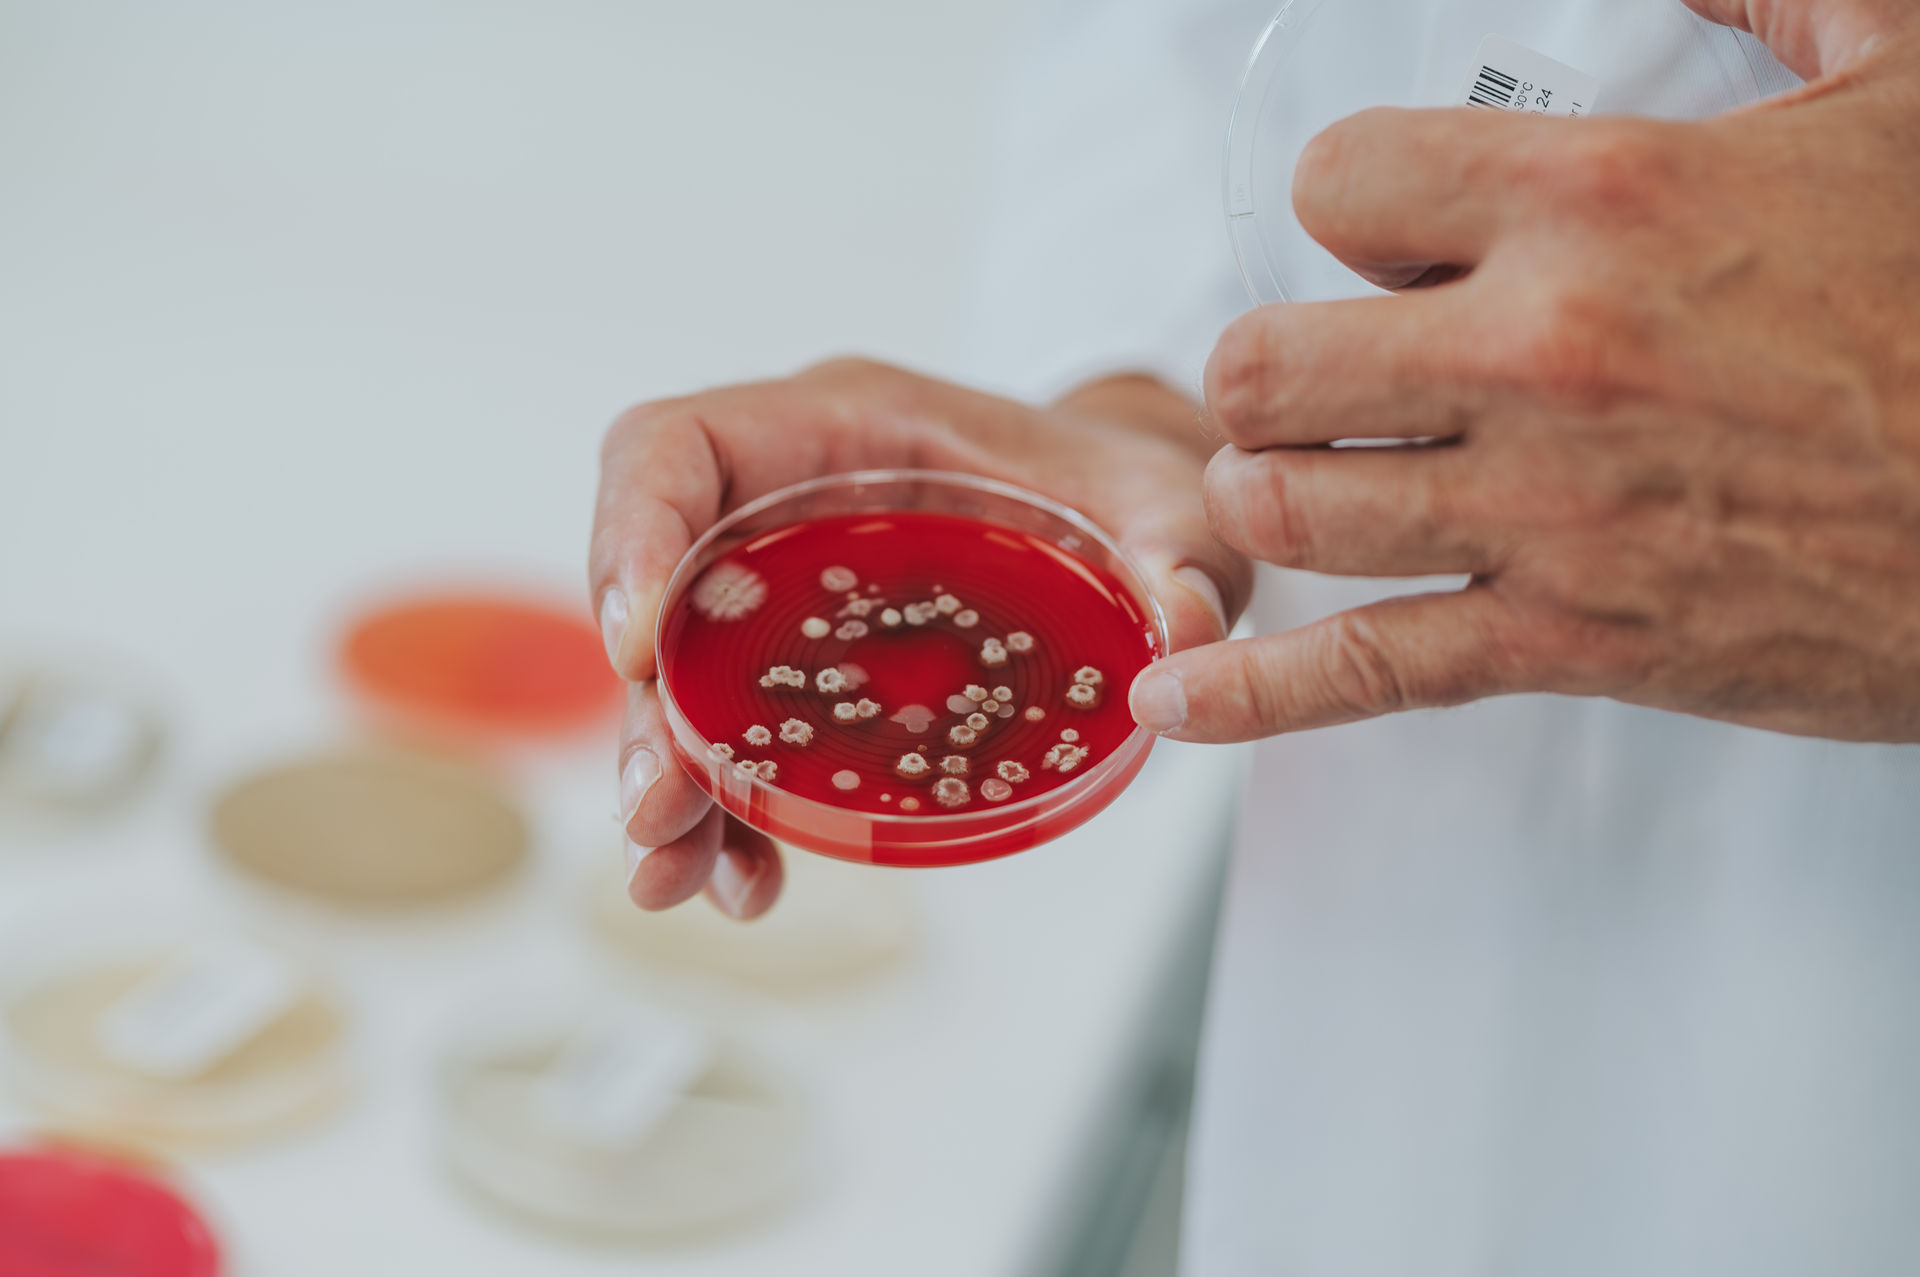
Petrischale

Datenschutzerklärung
1. Datenschutz auf einen Blick
Allgemeine Hinweise
Die folgenden Hinweise geben einen einfachen Überblick darüber, was mit Ihren personenbezogenen Daten passiert, wenn Sie unsere Website besuchen. Personenbezogene Daten sind alle Daten, mit denen Sie persönlich identifiziert werden können. Ausführliche Informationen zum Thema Datenschutz entnehmen Sie unserer unter diesem Text aufgeführten Datenschutzerklärung.
Datenerfassung auf unserer Webseite
Wer ist verantwortlich für die Datenerfassung auf dieser Webseite?
Die Datenverarbeitung auf dieser Webseite erfolgt durch den Webseitenbetreiber. Dessen Kontaktdaten können Sie dem Abschnitt „Hinweis zur Verantwortlichen Stelle“ in dieser Datenschutzerklärung entnehmen.
Wie erfassen wir Ihre Daten?
Ihre Daten werden zum einen dadurch erhoben, dass Sie uns diese mitteilen. Hierbei kann es sich z. B. um Daten handeln, die Sie in ein Kontaktformular eingeben.
Andere Daten werden automatisch beim Besuch der Webseite durch unsere IT-Systeme erfasst. Das sind vor allem technische Daten (z. B. Internetbrowser, Betriebssystem oder Uhrzeit des Seitenaufrufs). Die Erfassung dieser Daten erfolgt automatisch, sobald Sie unsere Webseite betreten.
Wofür nutzen wir Ihre Daten?
Ein Teil der Daten wird erhoben, um eine fehlerfreie Bereitstellung der Webseite zu gewährleisten. Andere Daten können zur Analyse Ihres Nutzerverhaltens verwendet werden.
Welche Rechte haben Sie bezüglich Ihrer Daten?
Sie haben jederzeit das Recht unentgeltlich Auskunft über Herkunft, Empfänger und Zweck Ihrer gespeicherten personenbezogenen Daten zu erhalten. Sie haben außerdem ein Recht, die Berichtigung, Sperrung oder Löschung dieser Daten zu verlangen. Hierzu sowie zu weiteren Fragen zum Thema Datenschutz können Sie sich jederzeit unter der im Impressum angegebenen Adresse an uns wenden. Des Weiteren steht Ihnen ein Beschwerderecht bei der zuständigen Aufsichtsbehörde zu.
Außerdem haben Sie das Recht, unter bestimmten Umständen die Einschränkung der Verarbeitung Ihrer personenbezogenen Daten zu verlangen. Details hierzu entnehmen Sie der Datenschutzerklärung unter „Recht auf Einschränkung der Verarbeitung“.
2. Hosting
Externes Hosting
Diese Website wird bei einem externen Dienstleister gehostet (Hoster). Die personenbezogenen Daten, dieauf dieser Website erfasst werden, werden auf den Servern des Hosters gespeichert. Hierbei kann es sich v. a. um IP-Adressen, Kontaktanfragen, Meta- und Kommunikationsdaten, Vertragsdaten, Kontaktdaten, Namen, Websitezugriffe und sonstige Daten, die über eine Website generiert werden, handeln.
Der Einsatz des Hosters erfolgt zum Zwecke der Vertragserfüllung gegenüber unseren potenziellen und bestehenden Kunden (Art. 6 Abs. 1 lit. b DSGVO) und im Interesse einer sicheren, schnellen und effizienten Bereitstellung unseres Online-Angebots durch einen professionellen Anbieter (Art. 6 Abs. 1 lit. f DSGVO).
Unser Hoster wird Ihre Daten nur insoweit verarbeiten, wie dies zur Erfüllung seiner Leistungspflichten erforderlich ist und unsere Weisungen in Bezug auf diese Daten befolgen.
Wir setzen folgenden Hoster ein:
Host Europe
Dienstanbieter: Host Europe GmbH, Hansestrasse 111, 51149 Köln
Internetseite: https://www.hosteurope.de/
Datenschutzerklärung: https://www.hosteurope.de/AGB/Datenschutzerklaerung/
Auftragsverarbeitung
Wir haben einen Vertrag über Auftragsverarbeitung (AVV) mit dem oben genannten Anbieter geschlossen. Hierbei handelt es sich um einen datenschutzrechtlich vorgeschriebenen Vertrag, der gewährleistet, dass dieser die personenbezogenen Daten unserer Websitebesucher nur nach unseren Weisungen und unter Einhaltung der DSGVO verarbeitet.
3. Allgemeine Hinweise und Pflichtinformationen
Datenschutz
Die Betreiber dieser Seiten nehmen den Schutz Ihrer persönlichen Daten sehr ernst. Wir behandeln Ihre personenbezogenen Daten vertraulich und entsprechend der gesetzlichen Datenschutzvorschriften sowie dieser Datenschutzerklärung.
Wenn Sie diese Website benutzen, werden verschiedene personenbezogene Daten erhoben. Personenbezogene Daten sind Daten, mit denen Sie persönlich identifiziert werden können. Die vorliegende Datenschutzerklärung erläutert, welche Daten wir erheben und wofür wir sie nutzen. Sie erläutert auch, wie und zu welchem Zweck das geschieht.
Wir weisen darauf hin, dass die Datenübertragung im Internet (z. B. bei der Kommunikation per E-Mail) Sicherheitslücken aufweisen kann. Ein lückenloser Schutz der Daten vor dem Zugriff durch Dritte ist nicht möglich.
Hinweis zur verantwortlichen Stelle
Die verantwortliche Stelle für die Datenverarbeitung auf dieser Website ist:
Institut Romeis Bad Kissingen GmbH
Schlimpfhofer Str. 21
D-97723 Oberthulba
Telefon: +49 (0) 9736 / 7516 - 0
E-Mail: info[at]institut-romeis [dot] de
Verantwortliche Stelle ist die natürliche oder juristische Person, die allein oder gemeinsam mit anderen über die Zwecke und Mittel der Verarbeitung von personenbezogenen Daten (z. B. Namen, E-Mail-Adressen o. Ä.) entscheidet.
Speicherdauer
Soweit innerhalb dieser Datenschutzerklärung keine speziellere Speicherdauer genannt wurde, verbleiben Ihre personenbezogenen Daten bei uns, bis der Zweck für die Datenverarbeitung entfällt. Wenn Sie ein berechtigtes Löschersuchen geltend machen oder eine Einwilligung zur Datenverarbeitung widerrufen, werden Ihre Daten gelöscht, sofern wir keine anderen rechtlich zulässigen Gründe für die Speicherung Ihrer personenbezogenen Daten haben (z. B. steuer- oder handelsrechtliche Aufbewahrungsfristen); im letztgenannten Fall erfolgt die Löschung nach Fortfall dieser Gründe.
Widerruf Ihrer Einwilligung zur Datenverarbeitung
Viele Datenverarbeitungsvorgänge sind nur mit Ihrer ausdrücklichen Einwilligung möglich. Sie können eine bereits erteilte Einwilligung jederzeit widerrufen. Dazu reicht eine formlose Mitteilung per E-Mail an uns. Die Rechtmäßigkeit der bis zum Widerruf erfolgten Datenverarbeitung bleibt vom Widerruf unberührt.
Widerspruchsrecht gegen die Datenerhebung in besonderen Fällen sowie gegen Direktwerbung (Art. 21 DSGVO)
Wenn die Datenverarbeitung auf Grundlage von Art. 6 Abs. 1 lit. e oder f DSGVO erfolgt, haben Sie jederzeit das Recht, aus Gründen, die sich aus Ihrer besonderen Situation ergeben, gegen die Verarbeitung Ihrer personenbezogenen Daten Widerspruch einzulegen; dies gilt auch für ein auf diese Bestimmungen gestütztes Profiling. Die jeweilige Rechtsgrundlage, auf denen eine Verarbeitung beruht, entnehmen Sie dieser Datenschutzerklärung. Wenn Sie Widerspruch einlegen, werden wir Ihre betroffenen personenbezogenen Daten nicht mehr verarbeiten, es sei denn, wir können zwingende schutzwürdige Gründe für die Verarbeitung nachweisen, die Ihre Interessen, Rechte und Freiheiten überwiegen oder die Verarbeitung dient der Geltendmachung, Ausübung oder Verteidigung von Rechtsansprüchen (Widerspruch nach Art. 21 Abs. 1 DSGVO).
Werden Ihre personenbezogenen Daten verarbeitet, um Direktwerbung zu betreiben, so haben Sie das Recht, jederzeit Widerspruch gegen die Verarbeitung Sie betreffender personenbezogener Daten zum Zwecke derartiger Werbung einzulegen; dies gilt auch für das Profiling, soweit es mit solcher Direktwerbung in Verbindung steht. Wenn Sie widersprechen, werden Ihre personenbezogenen Daten anschließend nicht mehr zum Zwecke der Direktwerbung verwendet (Widerspruch nach Art. 21 Abs. 2 DSGVO).
Beschwerderecht bei der zuständigen Aufsichtsbehörde
Im Falle von Verstößen gegen die DSGVO steht den Betroffenen ein Beschwerderecht bei einer Aufsichtsbehörde, insbesondere in dem Mitgliedstaat ihres gewöhnlichen Aufenthalts, ihres Arbeitsplatzes oder des Orts des mutmaßlichen Verstoßes zu. Das Beschwerderecht besteht unbeschadet anderweitiger verwaltungsrechtlicher oder gerichtlicher Rechtsbehelfe.
Recht auf Datenübertragbarkeit
Sie haben das Recht, Daten, die wir auf Grundlage Ihrer Einwilligung oder in Erfüllung eines Vertrags automatisiert verarbeiten, an sich oder an einen Dritten in einem gängigen, maschinenlesbaren Format aushändigen zu lassen. Sofern Sie die direkte Übertragung der Daten an einen anderen Verantwortlichen verlangen, erfolgt dies nur, soweit es technisch machbar ist.
SSL- bzw. TLS-Verschlüsselung
Diese Seite nutzt aus Sicherheitsgründen und zum Schutz der Übertragung vertraulicher Inhalte, wie zum Beispiel Bestellungen oder Anfragen, die Sie an uns als Seitenbetreiber senden, eine SSL-bzw. TLS-Verschlüsselung. Eine verschlüsselte Verbindung erkennen Sie daran, dass die Adresszeile des Browsers von „http://“ auf „https://“ wechselt und an dem Schloss-Symbol in Ihrer Browserzeile.
Wenn die SSL- bzw. TLS-Verschlüsselung aktiviert ist, können die Daten, die Sie an uns übermitteln, nicht von Dritten mitgelesen werden.
Auskunft, Löschung und Berichtigung
Sie haben im Rahmen der geltenden gesetzlichen Bestimmungen jederzeit das Recht auf unentgeltliche Auskunft über Ihre gespeicherten personenbezogenen Daten, deren Herkunft und Empfänger und den Zweck der Datenverarbeitung und ggf. ein Recht auf Berichtigung oder Löschung dieser Daten. Hierzu sowie zu weiteren Fragen zum Thema personenbezogene Daten können Sie sich jederzeit an uns wenden.
Recht auf Einschränkung der Verarbeitung
Sie haben das Recht, die Einschränkung der Verarbeitung Ihrer personenbezogenen Daten zu verlangen. Hierzu können Sie sich jederzeit unter der im Impressum angegebenen Adresse an uns wenden. Das Recht auf Einschränkung der Verarbeitung besteht in folgenden Fällen:
- Wenn Sie die Richtigkeit Ihrer bei uns gespeicherten personenbezogenen Daten bestreiten, benötigen wir in der Regel Zeit, um dies zu überprüfen. Für die Dauer der Prüfung haben Sie das Recht, die Einschränkung der Verarbeitung Ihrer personenbezogenen Daten zu verlangen.
- Wenn die Verarbeitung Ihrer personenbezogenen Daten unrechtmäßig geschah/geschieht, können Sie statt der Löschung die Einschränkung der Datenverarbeitung verlangen.
- Wenn wir Ihre personenbezogenen Daten nicht mehr benötigen, Sie sie jedoch zur Ausübung, Verteidigung oder Geltendmachung von Rechtsansprüchen benötigen, haben Sie das Recht, statt der Löschung die Einschränkung der Verarbeitung Ihrer personenbezogenen Daten zu verlangen.
- Wenn Sie einen Widerspruch nach Art. 21 Abs. 1 DSGVO eingelegt haben, muss eine Abwägung zwischen Ihren und unseren Interessen vorgenommen werden. Solange noch nicht feststeht, wessen Interessen überwiegen, haben Sie das Recht, die Einschränkung der Verarbeitung Ihrer personenbezogenen Daten zu verlangen.
Wenn Sie die Verarbeitung Ihrer personenbezogenen Daten eingeschränkt haben, dürfen diese Daten – von ihrer Speicherung abgesehen – nur mit Ihrer Einwilligung oder zur Geltendmachung, Ausübung oder Verteidigung von Rechtsansprüchen oder zum Schutz der Rechte einer anderen natürlichen oder juristischen Person oder aus Gründen eines wichtigen öffentlichen Interesses der Europäischen Union oder eines Mitgliedstaats verarbeitet werden.
Widerspruch gegen Werbe-E-Mails
Der Nutzung von im Rahmen der Impressumspflicht veröffentlichten Kontaktdaten zur Übersendung von nicht ausdrücklich angeforderter Werbung und Informationsmaterialien wird hiermit widersprochen. Die Betreiber der Seiten behalten sich ausdrücklich rechtliche Schritte im Falle der unverlangten Zusendung von Werbeinformationen, etwa durch Spam-E-Mails, vor.
4. Datenschutzbeauftrager
Für Ihre Anliegen steht unsere verantwortliche Stelle im Sinne des Datenschutzrechts gerne zur Verfügung:
Institut Romeis Bad Kissingen GmbH
Schlimpfhofer Str. 21
D-97723 Oberthulba
E-Mail: datenschutzbeauftragter[at]institut-romeis [dot] de
Fax: +49 (0) 9736 / 7516 - 29
5. Datenerfassung auf unserer Website
Cookies
Die Internetseiten verwenden teilweise so genannte Cookies. Cookies richten auf Ihrem Rechner keinen Schaden an und enthalten keine Viren. Cookies dienen dazu, unser Angebot nutzerfreundlicher, effektiver und sicherer zu machen. Cookies sind kleine Textdateien, die auf Ihrem Rechner abgelegt werden und die Ihr Browser speichert.
Die meisten der von uns verwendeten Cookies sind so genannte „Session-Cookies“. Sie werden nach Ende Ihres Besuchs automatisch gelöscht. Andere Cookies bleiben auf Ihrem Endgerät gespeichert bis Sie diese löschen. Diese Cookies ermöglichen es uns, Ihren Browser beim nächsten Besuch wiederzuerkennen.
Sie können Ihren Browser so einstellen, dass Sie über das Setzen von Cookies informiert werden und Cookies nur im Einzelfall erlauben, die Annahme von Cookies für bestimmte Fälle oder generell ausschließen sowie das automatische Löschen der Cookies beim Schließen des Browser aktivieren. Bei der Deaktivierung von Cookies kann die Funktionalität dieser Website eingeschränkt sein.
Cookies, die zur Durchführung des elektronischen Kommunikationsvorgangs oder zur Bereitstellung bestimmter, von Ihnen erwünschter Funktionen (z. B. Warenkorbfunktion) erforderlich sind, werden auf Grundlage von Art. 6 Abs. 1 lit. f DSGVO gespeichert. Der Websitebetreiber hat ein berechtigtes Interesse an der Speicherung von Cookies zur technisch fehlerfreien und optimierten Bereitstellung seiner Dienste. Soweit andere Cookies (z. B. Cookies zur Analyse Ihres Surfverhaltens) gespeichert werden, werden diese in dieser Datenschutzerklärung gesondert behandelt.
Server-Log-Dateien
Der Provider der Seiten erhebt und speichert automatisch Informationen in so genannten Server-Log-Dateien, die Ihr Browser automatisch an uns übermittelt. Dies sind:
- Browsertyp und Browserversion
- verwendetes Betriebssystem
- Referrer URL
- Hostname des zugreifenden Rechners
- Uhrzeit der Serveranfrage
- IP-Adresse
Eine Zusammenführung dieser Daten mit anderen Datenquellen wird nicht vorgenommen.
Die Erfassung dieser Daten erfolgt auf Grundlage von Art. 6 Abs. 1 lit. f DSGVO. Der Websitebetreiber hat ein berechtigtes Interesse an der technisch fehlerfreien Darstellung und der Optimierung seiner Website – hierzu müssen die Server-Log-Files erfasst werden.
Kontaktformular
Wenn Sie uns per Kontaktformular Anfragen zukommen lassen, werden Ihre Angaben aus dem Anfrageformular inklusive der von Ihnen dort angegebenen Kontaktdaten zwecks Bearbeitung der Anfrage und für den Fall von Anschlussfragen bei uns gespeichert. Diese Daten geben wir nicht ohne Ihre Einwilligung weiter.
Die Verarbeitung dieser Daten erfolgt auf Grundlage von Art. 6 Abs. 1 lit. b DSGVO, sofern Ihre Anfrage mit der Erfüllung eines Vertrags zusammenhängt oder zur Durchführung vorvertraglicher Maßnahmen erforderlich ist. In allen übrigen Fällen beruht die Verarbeitung auf unserem berechtigten Interesse an der effektiven Bearbeitung der an uns gerichteten Anfragen (Art. 6 Abs. 1 lit. f DSGVO) oder auf Ihrer Einwilligung (Art. 6 Abs. 1 lit. a DSGVO) sofern diese abgefragt wurde.
Die von Ihnen im Kontaktformular eingegebenen Daten verbleiben bei uns, bis Sie uns zur Löschungauffordern, Ihre Einwilligung zur Speicherung widerrufen oder der Zweck für die Datenspeicherung entfällt (z. B. nach abgeschlossener Bearbeitung Ihrer Anfrage). Zwingende gesetzliche Bestimmungen – insbesondere Aufbewahrungsfristen – bleiben unberührt.
Anfrage per E-Mail, Telefon oder Telefax
Wenn Sie uns per E-Mail, Telefon oder Telefax kontaktieren, wird Ihre Anfrage inklusive aller daraus hervorgehenden personenbezogenen Daten (Name, Anfrage) zum Zwecke der Bearbeitung Ihres Anliegens bei uns gespeichert und verarbeitet. Diese Daten geben wir nicht ohne Ihre Einwilligung weiter.
Die Verarbeitung dieser Daten erfolgt auf Grundlage von Art. 6 Abs. 1 lit. b DSGVO, sofern Ihre Anfrage mit der Erfüllung eines Vertrags zusammenhängt oder zur Durchführung vorvertraglicher Maßnahmen erforderlich ist. In allen übrigen Fällen beruht die Verarbeitung auf Ihrer Einwilligung (Art. 6 Abs. 1 lit. a DSGVO) und/oder auf unseren berechtigten Interessen (Art. 6 Abs. 1 lit. f DSGVO), da wir ein berechtigtes Interesse an der effektiven Bearbeitung der an uns gerichteten Anfragen haben.
Die von Ihnen an uns per Kontaktanfragen übersandten Daten verbleiben bei uns, bis Sie uns zur Löschung auffordern, Ihre Einwilligung zur Speicherung widerrufen oder der Zweck für die Datenspeicherung entfällt (z. B. nach abgeschlossener Bearbeitung Ihres Anliegens). Zwingende gesetzliche Bestimmungen – insbesondere gesetzliche Aufbewahrungsfristen – bleiben unberührt.
6. Datenschutzhinweise für direkte Bewerbungen
Mit den nachfolgenden Informationen möchten wir Ihnen einen Überblick über die Verarbeitung Ihrer personenbezogenen Daten als Bewerber oder Bewerberin auf ein Stellenangebot oder im Rahmen einer Initiativbewerbung geben.
I. Wer ist Verantwortlicher für die Datenverarbeitung im Bewerbungsverfahren?
Verantwortlicher im Sinne der DSGVO ist:
Institut Romeis Bad Kissingen GmbH
Schlimpfhofer Str. 21
D-97723 Oberthulba
Telefon: +49 (0) 9736 / 7516 - 0
E-Mail: info[at]institut-romeis [dot] de
Im Falle von Fragen zur Verarbeitung Ihrer personenbezogenen Daten im Rahmen des Bewerbungsprozesses oder zum Thema Datenschutz allgemein können sie sich jederzeit an unseren Datenschutzbeauftragten wenden.
Den Datenschutzbeauftragten erreichen Sie wie folgt: siehe unter Datenschutzbeauftagter
II. Welche Daten verarbeiten wir im Rahmen des Bewerbungsverfahrens?
Wir verarbeiten im Bewerbungsverfahren nur die personenbezogenen Daten, die Sie uns mit Ihrer Bewerbung zusenden. In der Regel handelt es sich hierbei um folgende Daten:
Name, Vorname und Geburtsdatum; Kontaktdaten (Telefonnummer, E-Mail-Adresse); Bewerbungsdaten wie Lebenslauf, Anschreiben und Zeugnisse; ggf. Angaben zum Gesundheitszustand oder zu einer Schwerbehinderung; ggf. ein Bewerbungsfoto; Kontodaten im Falle der Erstattung von Reisekosten; ggf. weitere Angaben, die Sie im Laufe des Bewerbungsgesprächs mitteilen.
III. Für welche Zwecke und mit welcher Rechtsgrundlage werden die Daten verarbeitet?
Die von Ihnen mitgeteilten Daten verarbeiten wir zur Prüfung Ihrer Bewerbung und Ihrer Eignung für die ausgeschriebene Stelle sowie zur Durchführung des Bewerbungsverfahrens. Rechtsgrundlage ist insoweit § 26 BDSG.
Zudem kann es erforderlich sein, dass Ihre Daten ggf. zur Verteidigung bzw. Durchsetzung von Rechtsansprüchen verarbeitet werden. In diesem Zweck liegt auch unser berechtigtes Interesse. Rechtsgrundlage ist für diese Verarbeitung Art. 6 Abs. 1 S. 1 lit. f DSGVO.
Sofern in Ihren Bewerbungsunterlagen besondere Kategorien personenbezogener Daten gem. Art. 9 Abs. 1 DSGVO enthalten sind, verarbeiten wird diese im Rahmen des Bewerbungsverfahrens zur Ausübung von Rechten oder der Erfüllung von Pflichten aus dem Arbeitsrecht, dem Recht der sozialen Sicherheit und dem Sozialschutz. Rechtsgrundlage ist insoweit Art. 6 Abs. 1 S. 1 lit. c DSGVO i.V.m. Art. 9 Abs. 2 lit. b DSGVO und § 26 Abs. 3 BDSG.
IV. Wann löschen wir Ihre Daten?
Ihre Daten werden spätestens 6 Monate nach Ende des Bewerbungsprozesses für die Stelle, auf die Sie sich beworben haben, gelöscht, sofern wir Sie nicht eingestellt haben. Haben wir mit Ihnen einen Arbeitsvertrag geschlossen, werden Ihre Bewerbungsdaten in die Personalakte aufgenommen.
V. An welche Empfänger werden Ihre Daten weitergegeben?
Ihre Bewerberdaten werden lediglich an die Stellen bzw. Personen im Unternehmen weitergegeben, die diese zur Durchführung des Bewerbungsprozesses und zur Prüfung der Bewerber benötigen.
Darüber hinaus können Ihre Bewerbungsdaten an Auftragsverarbeiter nach Art. 28 DSGVO weitergegeben werden. Folgende Auftragsverarbeiter wurden von uns im Rahmen des Bewerbungsverfahrens beauftragt:
Talency GmbH
Mönchsberger Str. 21
96515 Sonneberg
Eine Datenübermittlung in ein Drittland findet nicht statt.
VI. Ihre Betroffenenrechte
Als Betroffener der Datenverarbeitung stehen Ihnen die nachfolgenden Rechte zu. Sofern Sie von diesen Rechten Gebrauch machen wollen, wenden Sie sich hierzu bitte an unseren Datenschutzbeauftragten.
- Recht auf Auskunft nach Art. 15 DSGVO
- Recht auf Berichtigung nach Art. 16 DSGVO
- Recht auf Löschung Ihrer Daten nach Art. 17 DSGVO
- Recht auf Einschränkung der Datenverarbeitung nach Art. 18 DSGVO
- Recht auf Datenübertragbarkeit nach Art. 20 DSGVO
Zudem haben Sie nach Art. 21 Abs. 1 DSGVO das Recht, aus Gründen, die sich aus ihrer besonderen Situation ergeben, jederzeit gegen die Verarbeitung Ihrer personenbezogenen Daten, die aufgrund von Art. 6 Abs. 1 lit. f DSGVO erfolgt, Widerspruch einzulegen. Der Widerspruch ist in diesem Fall zu begründen.
VII. Beschwerderecht bei einer Aufsichtsbehörde
Wenn Sie der Ansicht sind, dass die Verarbeitung Ihrer personenbezogenen Daten gegen Datenschutzrecht verstößt, haben sie nach Art. 77 Abs. 1 DSGVO das Recht, sich bei einer Datenschutzaufsichtsbehörde zu beschweren. Hierzu gehört auch die für den Verantwortlichen zuständige Datenschutzaufsichtsbehörde:
Bayerisches Landesamt für Datenschutzaufsicht
Hausanschrift
Promenade 18
91522 Ansbach
Deutschland
Erreichbarkeit
Telefon: +49 (0) 981 180093-0
Telefax: +49 (0) 981 180093-800
E-Mail: poststelle[at]lda.bayern [dot] de (Es werden ausschließlich PDF-Dateien per Mail angenommen)
VIII. Bestehen einer automatisierten Entscheidungsfindung
Eine automatisierte Entscheidungsfindung nach Art. 22 Abs. 1 und 4 DSGVO – einschließlich Profiling – findet nicht statt.
7. Plugins und externe Tools
Einbindung von Diensten und Inhalten Dritter
Wir setzen innerhalb unseres Onlineangebotes auf Grundlage unserer berechtigten Interessen (d.h. Interesse an der Analyse, Optimierung und wirtschaftlichem Betrieb unseres Onlineangebotes im Sinne des Art. 6 Abs. 1 lit. f. DSGVO) Inhalts- oder Serviceangebote von Drittanbietern ein, um deren Inhalte und Services, wie z.B. Videos oder Schriftarten einzubinden (nachfolgend einheitlich bezeichnet als “Inhalte”).
Dies setzt immer voraus, dass die Drittanbieter dieser Inhalte, die IP-Adresse der Nutzer wahrnehmen, da sie ohne die IP-Adresse die Inhalte nicht an deren Browser senden könnten. Die IP-Adresse ist damit für die Darstellung dieser Inhalte erforderlich. Wir bemühen uns nur solche Inhalte zu verwenden, deren jeweilige Anbieter die IP-Adresse lediglich zur Auslieferung der Inhalte verwenden. Drittanbieter können ferner so genannte Pixel-Tags (unsichtbare Grafiken, auch als "Web Beacons" bezeichnet) für statistische oder Marketingzwecke verwenden. Durch die "Pixel-Tags" können Informationen, wie der Besucherverkehr auf den Seiten dieser Website ausgewertet werden. Die pseudonymen Informationen können ferner in Cookies auf dem Gerät der Nutzer gespeichert werden und unter anderem technische Informationen zum Browser und Betriebssystem, verweisende Webseiten, Besuchszeit sowie weitere Angaben zur Nutzung unseres Onlineangebotes enthalten, als auch mit solchen Informationen aus anderen Quellen verbunden werden.
YouTube mit erweitertem Datenschutz
Diese Website bindet Videos der YouTube ein. Betreiber der Seiten ist die Google Ireland Limited („Google“), Gordon House, Barrow Street, Dublin 4, Irland.
Wir nutzen YouTube im erweiterten Datenschutzmodus. Dieser Modus bewirkt laut YouTube, dass YouTube keine Informationen über die Besucher auf dieser Website speichert, bevor diese sich das Video ansehen. Die Weitergabe von Daten an YouTube-Partner wird durch den erweiterten Datenschutzmodus hingegen nicht zwingend ausgeschlossen. So stellt YouTube – unabhängig davon, ob Sie sich ein Video ansehen – eine Verbindung zum Google DoubleClick-Netzwerk her.
Sobald Sie ein YouTube-Video auf unserer Website starten, wird eine Verbindung zu den Servern von YouTube hergestellt. Dabei wird dem YouTube-Server mitgeteilt, welche unserer Seiten Sie besucht haben. Wenn Sie in Ihrem YouTube-Account eingeloggt sind, ermöglichen Sie YouTube, Ihr Surfverhalten direkt Ihrem persönlichen Profil zuzuordnen. Dies können Sie verhindern, indem Sie sich aus Ihrem YouTube-Account ausloggen.
Des Weiteren kann YouTube nach Starten eines Videos verschiedene Cookies auf Ihrem Endgerät speichern. Mit Hilfe dieser Cookies kann YouTube Informationen über Besucher unserer Website erhalten. Diese Informationen werden u. a. verwendet, um Videostatistiken zu erfassen, die Anwenderfreundlichkeit zu verbessern und Betrugsversuchen vorzubeugen. Die Cookies verbleiben auf Ihrem Endgerät, bis Sie sie löschen.
Gegebenenfalls können nach dem Start eines YouTube-Videos weitere Datenverarbeitungsvorgänge ausgelöst werden, auf die wir keinen Einfluss haben.
Die Nutzung von YouTube erfolgt im Interesse einer ansprechenden Darstellung unserer Online-Angebote. Dies stellt ein berechtigtes Interesse im Sinne von Art. 6 Abs. 1 lit. f DSGVO dar. Sofern eine entsprechende Einwilligung abgefragt wurde, erfolgt die Verarbeitung ausschließlich auf Grundlage von Art. 6 Abs. 1 lit. a DSGVO; die Einwilligung ist jederzeit widerrufbar.
Weitere Informationen über Datenschutz bei YouTube finden Sie in deren Datenschutzerklärung unter: https://policies.google.com/privacy?hl=de.
Google reCAPTCHA
Wir nutzen „Google reCAPTCHA“ (im Folgenden „reCAPTCHA“) auf unseren Websites. Anbieter ist die Google Ireland Limited („Google“), Gordon House, Barrow Street, Dublin 4, Irland.
Mit reCAPTCHA soll überprüft werden, ob die Dateneingabe auf unseren Websites (z. B. in einem Kontaktformular) durch einen Menschen oder durch ein automatisiertes Programm erfolgt. Hierzu analysiert reCAPTCHA das Verhalten des Websitebesuchers anhand verschiedener Merkmale. Diese Analyse beginnt automatisch, sobald der Websitebesucher die Website betritt. Zur Analyse wertet reCAPTCHA verschiedene Informationen aus (z. B. IP-Adresse, Verweildauer des Websitebesuchers auf der Website oder vom Nutzer getätigte Mausbewegungen). Die bei der Analyse erfassten Daten werden an Google weitergeleitet.
Die reCAPTCHA-Analysen laufen vollständig im Hintergrund. Websitebesucher werden nicht darauf hingewiesen, dass eine Analyse stattfindet.
Die Speicherung und Analyse der Daten erfolgt auf Grundlage von Art. 6 Abs. 1 lit. f DSGVO. Der Websitebetreiber hat ein berechtigtes Interesse daran, seine Webangebote vor missbräuchlicher automatisierter Ausspähung und vor SPAM zu schützen. Sofern eine entsprechende Einwilligung abgefragt wurde, erfolgt die Verarbeitung ausschließlich auf Grundlage von Art. 6 Abs. 1 lit. a DSGVO; die Einwilligung ist jederzeit widerrufbar.
Weitere Informationen zu Google reCAPTCHA entnehmen Sie den Google-Datenschutzbestimmungen und den Google Nutzungsbedingungen unter folgenden Links:
https://policies.google.com/privacy?hl=de und https://policies.google.com/terms?hl=de.
Font Awesome (lokales Hosting)
Diese Seite nutzt zur einheitlichen Darstellung von Schriftarten Font Awesome. Font Awesome ist lokal installiert. Eine Verbindung zu Servern von Fonticons, Inc. findet dabei nicht statt.
Weitere Informationen zu Font Awesome finden Sie in der Datenschutzerklärung für Font Awesome unter: https://fontawesome.com/privacy.
Meta Conversion Pixel
Teile unserer Bewerbungs-Webseite verwenden das “Conversion-Pixel“ bzw. Besucheraktions-Pixel der Meta Platforms, Inc., 1601 South California Avenue, Palo Alto, CA 94304, USA (hier: Meta). Dabei handelt es sich um eine Tracking-Technologie der Kategorie “Optionale Einstellungen“.
Mittels Aufrufs dieses Pixels aus Ihrem Browser ist es Meta Platforms, Inc. möglich, zu erkennen, ob eine Meta-Werbemaßnahme erfolgreich war, etwa ob sie zu einem Vertragsschluss geführt hat. Seitens Meta Inc. erhalten wir hierzu ausschließlich statistische Daten ohne konkreten Personenbezug. Dies ist für uns wichtig, um die Wirksamkeit unserer Meta-Werbemaßnahmen für statistische Zwecke und zur Marktforschung zu erfassen. Für den Fall, dass Sie Nutzer von Angeboten der Meta Platforms, Inc. sind, weisen wir zudem auf deren Datenschutzinformationen https://www.facebook.com/about/privacy/ hin.
Das Meta Conversion Pixel wird nur nach Ihrer vorherigen Einwilligung in die Kategorie „Optionale Einstellungen“ verwendet. Rechtsgrundlage hierfür stellt Art. 6 Abs. 1 lit. a) DSGVO in Verbindung mit Ihrer Einwilligung dar.
Meta Custom Wesite Audience
Unsere Bewerbungs-Webseite verwendet „Website Custom Audiences“-Pixel des Social-Media-Dienstes Facebook, bereitgestellt durch Meta Platforms, Inc. Für diese Verwendung haben wir sogenannte Zählpixel auf unserer Seite eingebaut. Bei Aufruf unserer Webseite erfolgt über das Zählpixel eine direkte Verbindung zwischen Ihrem Browser und einem Meta-Server.
Meta Platforms, Inc. erhält dadurch von Ihrem Browser neben weiteren die Information, von welchem Endgerät Sie unsere Seite aufgerufen haben. Sofern Sie einen Facebook oder Instagram-Account besitzen und mit diesem bei Metas Social-Media-Dienst angemeldet sind, kann Meta Platforms, Inc. durch diese Verknüpfung den Besuch dieser Webseite Ihrem Account zuordnen. Allerdings haben wir als Betreiber der Webseite keine Kenntnis vom Inhalt der übermittelten Daten sowie deren Nutzung durch Meta Platforms, Inc. Uns steht lediglich die Auswahlmöglichkeit zur Verfügung, welchen Gruppen von Personen mit einem Facebook- oder Instagram-Account gegenüber (nach demografischen und interessenbasierten Kriterien) Werbemaßnahmen ausgespielt werden sollen. Die Nutzung von Custom Audiences erfolgt dabei auf der Stufe geringer Eingriffsintensität, da wir keine Datensätze, insbesondere keine E-Mailadressen, von Kunden und Interessierten an Meta übermitteln. Für weitere Informationen verweisen wir auf die Datenschutzerklärung von Meta unter https://www.facebook.com/about/privacy/
Meta Custom Audience wird nur nach Ihrer vorherigen Einwilligung in die Kategorie „Optionale Einstellungen“ verwendet. Rechtsgrundlage hierfür stellt Art. 6 Abs. 1 lit. a) DSGVO in Verbindung mit Ihrer Einwilligung dar.
Online-Quiz / Schnellbewerbungsprozess
Für die Bereitstellung unseres Online-Quiz / Schnellbewerbungsprozess setzen wir einen externen Dienstleister ein: Perspective Software GmbH, Mailbox 659770, D-96035 Bamberg (im Folgenden „Perspective“). Perspective selbst speichert Ihre Daten ausschließlich auf europäischen Servern. Allerdings besteht die Möglichkeit, dass Ihre Daten für Einrichtungen in den Vereinigten Staaten von Amerika zugänglich sind, da Perspective Unterverarbeiter mit Sitz in den USA einsetzt. Da die Kommission der Europäischen Union festgelegt hat, dass die Datenschutzgesetze der Vereinigten Staaten kein angemessenes Schutzniveau für personenbezogene Daten gewährleisten, die von betroffenen Personen in der Europäischen Union erhoben werden, bietet Perspective für die Datenübermittlung in die Vereinigten Staaten zusätzliche Maßnahmen und Garantien gemäß den Anforderungen der DSGVO, um ein angemessenes Schutzniveau zu gewährleisten. Beispielsweise durch den Abschluss von Standardvertragsklauseln zwischen Perspective und den Unterverarbeitern.
I. Beschreibung und Umfang der Datenverarbeitung
Perspective verarbeitet für uns Ihre Daten, damit wir Ihnen unsere Online-Dienste zur Verfügung stellen können. Zu diesem Zweck wird Perspective Ihre IP-Adresse automatisch übermittelt, um die Inhalte und Funktionen unserer Online-Dienste an Ihren Browser oder Ihr Endgerät zu übermitteln. Folgende Daten können erhoben werden:
- Informationen über den Browsertyp und die verwendete Version
- Das Betriebssystem Ihres Computers
- Der Internet-Service-Provider den Sie nutzen
- Die IP-Adresse Ihres Endgeräts
- Datum und Uhrzeit Ihres Zugriffs auf den Funnel
- Websites, von denen Sie auf unsere Internetseite kamen („Referrer“)
II. Rechtsgrundlage für die Datenverarbeitung
Perspective speichert die unter I. genannten Daten in sog. Logfiles (Protokolldateien). Dies erfolgt zur Sicherstellung
- der Gewährleistung eines reibungslosen Verbindungsaufbaus der Website,
- der Gewährleistung einer komfortablen Nutzung unserer Website,
- der Auswertung der Systemsicherheit und -stabilität sowie
- zu weiteren administrativen Zwecken.
Die vorübergehende Speicherung der IP-Adresse durch das System ist darüber hinaus notwendig, um eine Auslieferung der Website an Ihren Rechner zu ermöglichen. Hierfür muss die IP-Adresse Ihres Computers für die Dauer der Sitzung gespeichert bleiben. In diesen Zwecken liegt auch unser berechtigtes Interesse an der Datenverarbeitung. Rechtsgrundlage für die Datenverarbeitung ist damit Art. 6 Abs. 1 S. 1 lit. f DSGVO.
III. Dauer der Verarbeitung
Die von Perspective verarbeiteten personenbezogenen Daten werden gelöscht, sobald sie für die Erreichung des Zweckes ihrer Erhebung nicht mehr erforderlich
sind:
- Im Falle der Erfassung der Daten zur Bereitstellung der Website ist dies der Fall, wenn die jeweilige Sitzung beendet ist.
- Im Falle der Speicherung der IP-Adresse in Logfiles ist dies nach spätestens 7 Tagen der Fall.
IV. Betroffenenrechte
Sie haben jederzeit das Recht, unentgeltlich Auskunft über Herkunft, Empfänger und Zweck Ihrer gespeicherten personenbezogenen Daten zu erhalten. Sie haben außerdem ein Recht, die Berichtigung, Sperrung oder Löschung dieser Daten zu verlangen. Hierzu sowie zu weiteren Fragen zum Thema Datenschutz können Sie sich jederzeit unter der im Impressum angegebenen Adresse an uns wenden. Des Weiteren steht Ihnen bei Verstößen gegen die DSGVO ein Beschwerderecht bei der zuständigen Aufsichtsbehörde zu. Weil die Datenverarbeitung auf Grundlage von Art. 6 Abs. 1 S. 1 lit. f DSGVO erfolgt, haben Sie jederzeit das Recht, aus Gründen, die sich aus Ihrer besonderen Situation ergeben, gegen die Verarbeitung Ihrer personenbezogenen Daten Widerspruch einzulegen. Wenn Sie Widerspruch einlegen, werden wir Ihre betroffenen personenbezogenen Daten nicht mehr verarbeiten, es sei denn, wir können zwingende schutzwürdige Gründe für die Verarbeitung nachweisen, die Ihre Interessen, Rechte und Freiheiten überwiegen oder die Verarbeitung dient der Geltendmachung, Ausübung oder Verteidigung von Rechtsansprüchen (Widerspruch nach Art. 21 Abs. 1 DSGVO). Da die Erfassung der Daten zur Bereitstellung der Website und die Speicherung der Daten in Logfiles für den Betrieb unserer Internetseite zwingend erforderlich ist, dürfte zumeist keine Widerspruchsmöglichkeit für Sie bestehen. Außerdem haben Sie das Recht, unter bestimmten Umständen die Einschränkung der Verarbeitung Ihrer personenbezogenen Daten zu verlangen. Das Recht auf Einschränkung der Verarbeitung besteht in folgenden Fällen:
- Wenn Sie die Richtigkeit Ihrer bei uns gespeicherten personenbezogenen Daten bestreitest, benötigen wir in der Regel Zeit, um dies zu überprüfen. Für die Dauer der Prüfung haben Sie das Recht, die Einschränkung der Verarbeitung Ihrer personenbezogenen Daten zu verlangen.
- Wenn die Verarbeitung Ihrer personenbezogenen Daten unrechtmäßig geschah / geschieht, können Sie statt der Löschung die Einschränkung der Datenverarbeitung verlangen.
- Wenn wir Ihre personenbezogenen Daten nicht mehr benötigen, Sie sie jedoch zur Ausübung, Verteidigung oder Geltendmachung von Rechtsansprüchen benötigen, haben Sie das Recht, statt der Löschung die Einschränkung der Verarbeitung Ihrer personenbezogenen Daten zu verlangen.
- Wenn Sie einen Widerspruch nach Art. 21 Abs. 1 DSGVO eingelegt haben, muss eine Abwägung zwischen Ihren und unseren Interessen vorgenommen werden. Solange noch nicht feststeht, wessen Interessen überwiegen, haben Sie das Recht, die Einschränkung der Verarbeitung Ihrer personenbezogenen Daten zu verlangen.
Wenn Sie die Verarbeitung Ihrer personenbezogenen Daten eingeschränkt hast, dürfen diese Daten – von ihrer Speicherung abgesehen – nur mit Ihrer Einwilligung oder zur Geltendmachung, Ausübung oder Verteidigung von Rechtsansprüchen oder zum Schutz der Rechte einer anderen natürlichen oder juristischen Person oder aus Gründen eines wichtigen öffentlichen Interesses der Europäischen Union oder eines Mitgliedstaats verarbeitet werden.
Kontakt- und Anfrageverwaltung für den Bewerbungsprozess
Für die Bereitstellung von Kontakt-, Anfrage- oder Bewerbungsformularen setzen wir einen externen Dienstleister ein: Perspective Software GmbH, Mailbox 659770, D-96035 Bamberg (im Folgenden „Perspective“). Perspective selbst speichert Ihre Daten ausschließlich auf europäischen Servern. Allerdings besteht die Möglichkeit, dass Ihre Daten für Einrichtungen in den Vereinigten Staaten von Amerika zugänglich sind, weil Perspective Unterverarbeiter mit Sitz in den USA einsetzt. Da die Kommission der Europäischen Union festgelegt hat, dass die Datenschutzgesetze der Vereinigten Staaten kein angemessenes Schutzniveau für personenbezogene Daten gewährleisten, die von betroffenen Personen in der Europäischen Union erhoben werden, bietet Perspective für die Datenübermittlung in die Vereinigten Staaten zusätzliche Maßnahmen und Garantien gemäß den Anforderungen der DSGVO, um ein angemessenes Schutzniveau zu gewährleisten. Beispielsweise durch den Abschluss von Standardvertragsklauseln zwischen Perspective und den Unterverarbeitern.
I. Beschreibung und Umfang der Datenverarbeitung
Bei der Nutzung der Kontakt-, Anfrage- oder Bewerbungsformularen von Perspective werden folgende Daten an die Server von Perspective übermittelt:
- Datum und Uhrzeit des Zugriffs
- Websites, von denen Sie auf unsere Internetseite kamen („Referrer“)
- Kontextinformationen (z.B. Buttonklicks auf den Seiten, getroffene Auswahlen auf den Seiten)
- Inhalte aller ausgefüllten Textfelder (bspw. Kontaktdaten, wie Ihr Name oder Ihre Anschrift, oder andere personenbezogene Daten, abhängig von der im konkreten Textfeld abgebildeten Fragestellung)
- Von Ihnen hochgeladene Dateien
II. Zweck Rechtsgrundlage der Datenverarbeitung
Der Zweck dieser Datenverarbeitung ist es, die von Ihnen aufgenommene Kommunikation zu gewährleisten. Die Verarbeitung Ihrer Daten aus Kontakt- bzw. Anfrage- oder Bewerbungsformularen erfolgt somit zunächst aufgrund Ihrer Einwilligung. Die Rechtsgrundlage ist Art. 6 Abs. 1 S. 1 lit. a DSGVO. Erfolgt über ein Anfrageformular eine Vertragsanbahnung, ist Rechtsgrundlage zudem Art. 6 Abs. 1 S. 1 lit. b DSGVO. Rechtsgrundlage für die Verarbeitung der Daten in einem Bewerbungsformular kann neben Art. 6 Abs. 1 S. 1 lit. f DSGVO auch Art. 88 DSGVO i.V.m. 26 BDSG sein.
III. Dauer der Verarbeitung
Ihre personenbezogenen Daten werden so lange aufbewahrt, wie sie zur Erfüllung des Verarbeitungszwecks erforderlich sind, bzw. bis Sie Ihre Einwilligung widerrufen. Ausgenommen von diesem Grundsatz sind solche Daten, die Perspective aufgrund gesetzlicher Verpflichtungen aufbewahren muss. Dazu gehören z.B. die handels- und steuerrechtlichen Aufbewahrungspflichten. Diese Aufbewahrungsfristen betragen – derzeit – bis zu zehn Jahre
IV. Betroffenenrechte
Sie haben jederzeit das Recht, unentgeltlich Auskunft über Herkunft, Empfänger und Zweck Ihrer gespeicherten personenbezogenen Daten zu erhalten. Sie haben außerdem ein Recht, die Berichtigung, Sperrung oder Löschung dieser Daten zu verlangen. Hierzu sowie zu weiteren Fragen zum Thema Datenschutz können Sie sich jederzeit unter der im Impressum angegebenen Adresse an uns wenden. Des Weiteren steht Ihnen bei Verstößen gegen die DSGVO ein Beschwerderecht bei der zuständigen Aufsichtsbehörde zu.
Ihre Einwilligung in die Datenverarbeitung können Sie jederzeit durch formlose Mitteilung an uns (etwa per E-Mail) widerrufen. Durch den Widerruf wird die Rechtmäßigkeit der aufgrund der Einwilligung bis zum Widerruf erfolgten Verarbeitung nicht berührt.
Außerdem haben Sie das Recht, unter bestimmten Umständen die Einschränkung der Verarbeitung Ihrer personenbezogenen Daten zu verlangen. Das Recht auf Einschränkung der Verarbeitung besteht in folgenden Fällen:
- Wenn Sie die Richtigkeit Ihrer bei uns gespeicherten personenbezogenen Daten bestreiten, benötigen wir in der Regel Zeit, um dies zu überprüfen. Für die Dauer der Prüfung haben Sie das Recht, die Einschränkung der Verarbeitung Ihrer personenbezogenen Daten zu verlangen.
- Wenn die Verarbeitung Ihrer personenbezogenen Daten unrechtmäßig geschah / geschieht, können Sie statt der Löschung die Einschränkung der Datenverarbeitung verlangen.
- Wenn wir Ihre personenbezogenen Daten nicht mehr benötigen, Sie sie jedoch zur Ausübung, Verteidigung oder Geltendmachung von Rechtsansprüchen benötigen, haben Sie das Recht, statt der Löschung die Einschränkung der Verarbeitung Ihrer personenbezogenen Daten zu verlangen.
- Wenn Sie einen Widerspruch nach Art. 21 Abs. 1 DSGVO eingelegt haben, muss eine Abwägung zwischen Ihren und unseren Interessen vorgenommen werden. Solange noch nicht feststeht, wessen Interessen überwiegen, haben Sie das Recht, die Einschränkung der Verarbeitung Ihrer personenbezogenen Daten zu verlangen.
Wenn Sie die Verarbeitung Ihrer personenbezogenen Daten eingeschränkt hast, dürfen diese Daten – von ihrer Speicherung abgesehen – nur mit Ihrer Einwilligung oder zur Geltendmachung, Ausübung oder Verteidigung von Rechtsansprüchen oder zum Schutz der Rechte einer anderen natürlichen oder juristischen Person oder aus Gründen eines wichtigen öffentlichen Interesses der Europäischen Union oder eines Mitgliedstaats verarbeitet werden.
Stand: Mai 2025